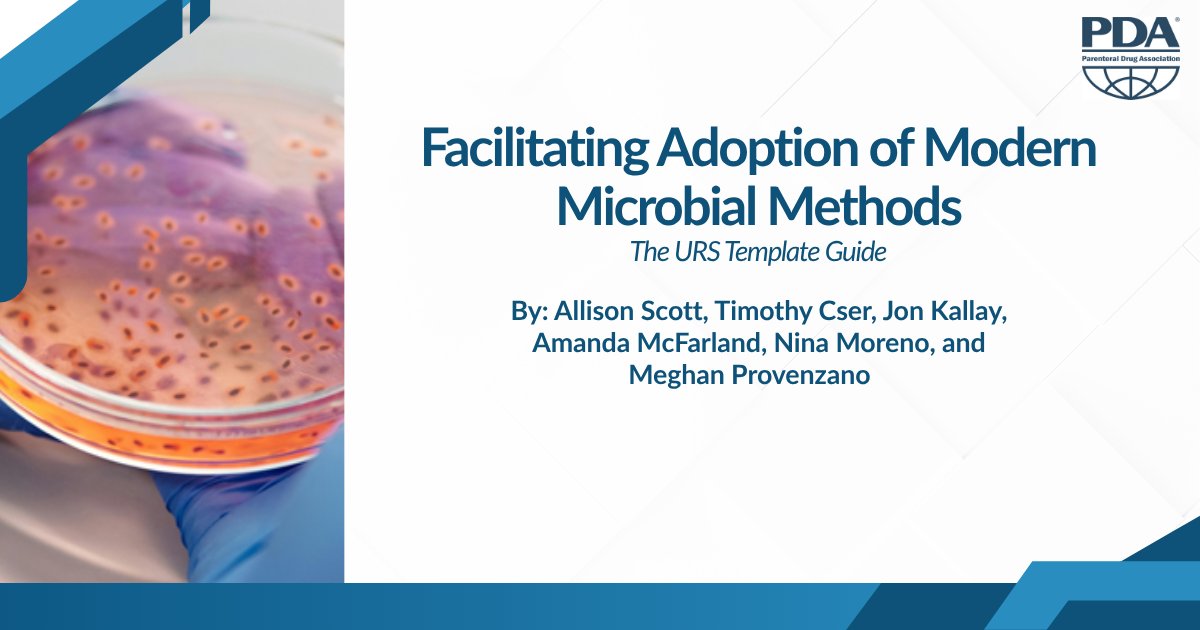

PDA
@pdaonline
PDA is a leading global provider of #science, technology, and regulatory information and education for the #pharmaceutical and #biopharmaceutical community.
ID: 3331528055
https://www.pda.org 17-06-2015 17:18:23
6,6K Tweet
1,1K Followers
348 Following